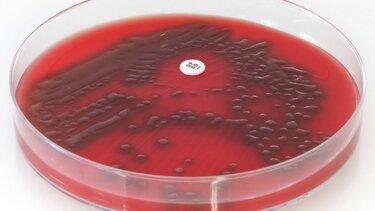
«Πόλεμος» φαρμακοποιών με εργαστηριακούς γιατρούς για τα strep-test

«Πόλεμος» φαρμακοποιών με εργαστηριακούς γιατρούς για τα strep-test
Στα Δικαστήρια οδηγούνται από τους φαρμακοποιούς οι εργαστηριακοί γιατροί Δ. Ελλάδας μετά τις καταγγελίες τους για τα strep-test, μετά και τις αντιδράσεις που είχαν εκφράσει για τα γρήγορα τεστ του κορωνοϊού
Σε μήνυση για συκοφαντική δυσφήμιση καταφεύγουν οι φαρμακοποιοί εναντίον των εργαστηριακών γιατρών Δυτικής Ελλάδας για την αντίδρασή τους στην πώληση των γρήγορων τεστ για τον στρεπτόκοκκο strep-test από τα φαρμακεία.
«Για άλλη μια φορά ο Σύνδεσμος Ιδιωτών Εργαστηριακών Ιατρών Δυτικής Ελλάδος (Σ.ΙΔ.Ε.Ι.Δ.ΕΛ) επανέρχεται με συκοφαντικές και αντιεπιστημονικές δηλώσεις και με ανυπόστατους και συντεχνιακούς χαρακτηρισμούς εις βάρος των φαρμακοποιών», επισημαίνει ο Πανελλήνιος Φαρμακευτικός Σύλλογος, ο οποίος αποφάσισε να προχωρήσει σε μήνυση για συκοφαντική δυσφήμιση του φαρμακευτικού κλάδου, χωρίς να προηγηθούν άλλες εξωδικαστικές ενέργειες, επειδή ο συγκεκριμένος σύνδεσμος εξακολουθεί να βάλλει με ευθείες αναφορές, τις οποίες έχει επαναλάβει και στο παρελθόν, προσβάλοντας το σύνολο των φαρμακοποιών της χώρας.
Στη σχετική ανακοίνωσή του ο ΠΦΣ σημειώνει πως «Οι αναφορές στις επιστολές τους, ξεφεύγουν ακόμα και από τα όρια της γραφικότητας καθόσον, όπως όλοι θυμούνται, ήταν εκείνοι που αντέδρασαν, καθαρά για οικονομικούς λόγους, για τη διάθεση των self-test και για τη διενέργεια των rapid test από τα φαρμακεία που όπως αποδείχθηκε, συνέβαλαν αποφασιστικά στην επιδημιολογική επιτήρηση κατά την πανδημία, στη διασφάλιση της Δημόσιας Υγείας και τελικά στην επανεκκίνηση της οικονομίας και της κοινωνίας.
Όμως όλες αυτές οι αναφορές του Σ.ΙΔ.Ε.Ι.Δ.ΕΛ έπεσαν στο κενό, αφού όπως αποδείχθηκε ο ρόλος των φαρμακοποιών κατά την πανδημία ήταν καταλυτικός, καθώς 24 ώρες το εικοσιτετράωρο και 7 μέρες την εβδομάδα για όλες τις μέρες του χρόνου, το δίκτυο των φαρμακείων διασφαλίζει την πρόσβαση των πολιτών στις υπηρεσίες διάθεσης και διενέργειας των test για την ανίχνευση του κοροναϊού, που οδηγεί στην έγκαιρη έναρξη της αντιϊκής αγωγής».
Όσο για την αναφορά των εργαστηριακών γιατρών περί «εγκληματικής ενέργειας», ο ΠΦΣ τονίζει πως το strep test διακινείται νομίμως από τα φαρμακεία, καθώς έχει εγκριθεί η κυκλοφορία του από τον ΕΟΦ.
Κατά αυτόν τον τρόπο παρέχεται η δυνατότητα στον θεράποντα ιατρό που διενεργεί το test, της άμεσης και τεκμηριωμένης διάγνωσης προκειμένου να προχωρήσει στην κατάλληλη φαρμακευτική αγωγή για τον ασθενή, οποιαδήποτε ώρα και μέρα, ακόμα και όταν τα μικροβιολογικά εργαστήρια είναι κλειστά, ακόμα και στις παραμεθόριες περιοχές όπου αυτά δεν υπάρχουν. Η σημασία της έγκαιρης διάγνωσης είναι αυτή που τελικά σώζει ζωές.
Επίσης στις αναφορές του συγκεκριμένου Συνδέσμου Δυτικής Ελλάδας περί «ιατρικής πράξης» αναφέρουν ότι το strep test σε όλες τις χώρες της Ευρωπαϊκής Ένωσης διενεργείται από επιστήμονες υγείας, όπως είναι και οι φαρμακοποιοί που εργάζονται στα φαρμακεία της κοινότητας, οι οποίοι εφαρμόζουν και τηρούν τα υγειονομικά πρωτόκολλα.
Ο Πανελλήνιος Φαρμακευτικός Σύλλογος θεωρεί ότι η υγειονομική κρίση που βιώνουμε, με τα χιλιάδες θύματα, δεν μπορεί να αποτελέσει πεδίο συνδικαλιστικής αντιπαράθεσης και ότι «όλοι οι Υγειονομικοί οφείλουμε να συστρατευθούμε και να στηρίξουμε την κοινωνία και την πολιτεία στον αγώνα αυτό».
- Kατάθλιψη: Ποιες γυναίκες κινδυνεύουν να την εμφανίσουν κατά 130%
- Τα φρούτα που ξανανιώνουν τις αρτηρίες και την καρδιά
- Νέα έρευνα: Οι ξενύχτηδες πεθαίνουν νωρίτερα



















